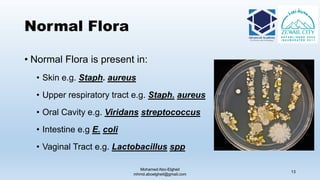
Normal Flora
• Normal Flora is present in:
• Skin e.g. Staph. aureus
• Upper respiratory tract e.g. Staph. aureus
• Oral Cavity e.g. Viridans streptococcus
• Intestine e.g E. coli
• Vaginal Tract e.g. Lactobacillus spp
Mohamed Abo-Elgheit
mhmd.aboelgheit@gmail.com
13
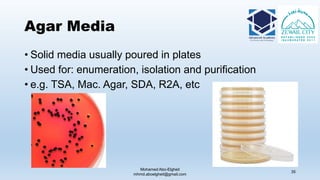
Agar Media
Mohamed Abo-Elgheit
mhmd.aboelgheit@gmail.com
35
• Solid media usually poured in plates
• Used for: enumeration, isolation and purification
• e.g. TSA, Mac. Agar, SDA, R2A, etc

The document is a comprehensive lecture on pharmaceutical microbiology, outlining the role of microbiology labs in the pharmaceutical industry, microbiological tests, and the career path for microbiologists. It covers key concepts such as aseptic techniques, types of microorganisms, microbiological analysis, and good manufacturing practices. Additionally, it includes details about the microbiology lab setup, equipment, and various testing methodologies essential for ensuring the safety and efficacy of pharmaceutical products.